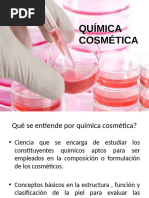

0% encontró este documento útil (0 votos)
97 vistas10 páginasToxicidad de Parabenos en Cremas Hidratantes
Este documento presenta una actividad entregable para un curso de técnicas y métodos de aprendizaje investigativo. Incluye la formulación de un problema de investigación sobre la toxicidad de parabenos en cremas hidratantes y su evaluación con organismos acuáticos. También incluye el objetivo general, la justificación, el marco teórico con conceptos sobre cremas hidratantes, parabenos y estructura de la piel, así como antecedentes de investigaciones previas sobre la seguridad de los parabenos.
Cargado por
Yessenia Rocio Sánchez NayvaresDerechos de autor
© © All Rights Reserved
Nos tomamos en serio los derechos de los contenidos. Si sospechas que se trata de tu contenido, reclámalo aquí.
Formatos disponibles
Descarga como DOCX, PDF, TXT o lee en línea desde Scribd
0% encontró este documento útil (0 votos)
97 vistas10 páginasToxicidad de Parabenos en Cremas Hidratantes
Este documento presenta una actividad entregable para un curso de técnicas y métodos de aprendizaje investigativo. Incluye la formulación de un problema de investigación sobre la toxicidad de parabenos en cremas hidratantes y su evaluación con organismos acuáticos. También incluye el objetivo general, la justificación, el marco teórico con conceptos sobre cremas hidratantes, parabenos y estructura de la piel, así como antecedentes de investigaciones previas sobre la seguridad de los parabenos.
Cargado por
Yessenia Rocio Sánchez NayvaresDerechos de autor
© © All Rights Reserved
Nos tomamos en serio los derechos de los contenidos. Si sospechas que se trata de tu contenido, reclámalo aquí.
Formatos disponibles
Descarga como DOCX, PDF, TXT o lee en línea desde Scribd